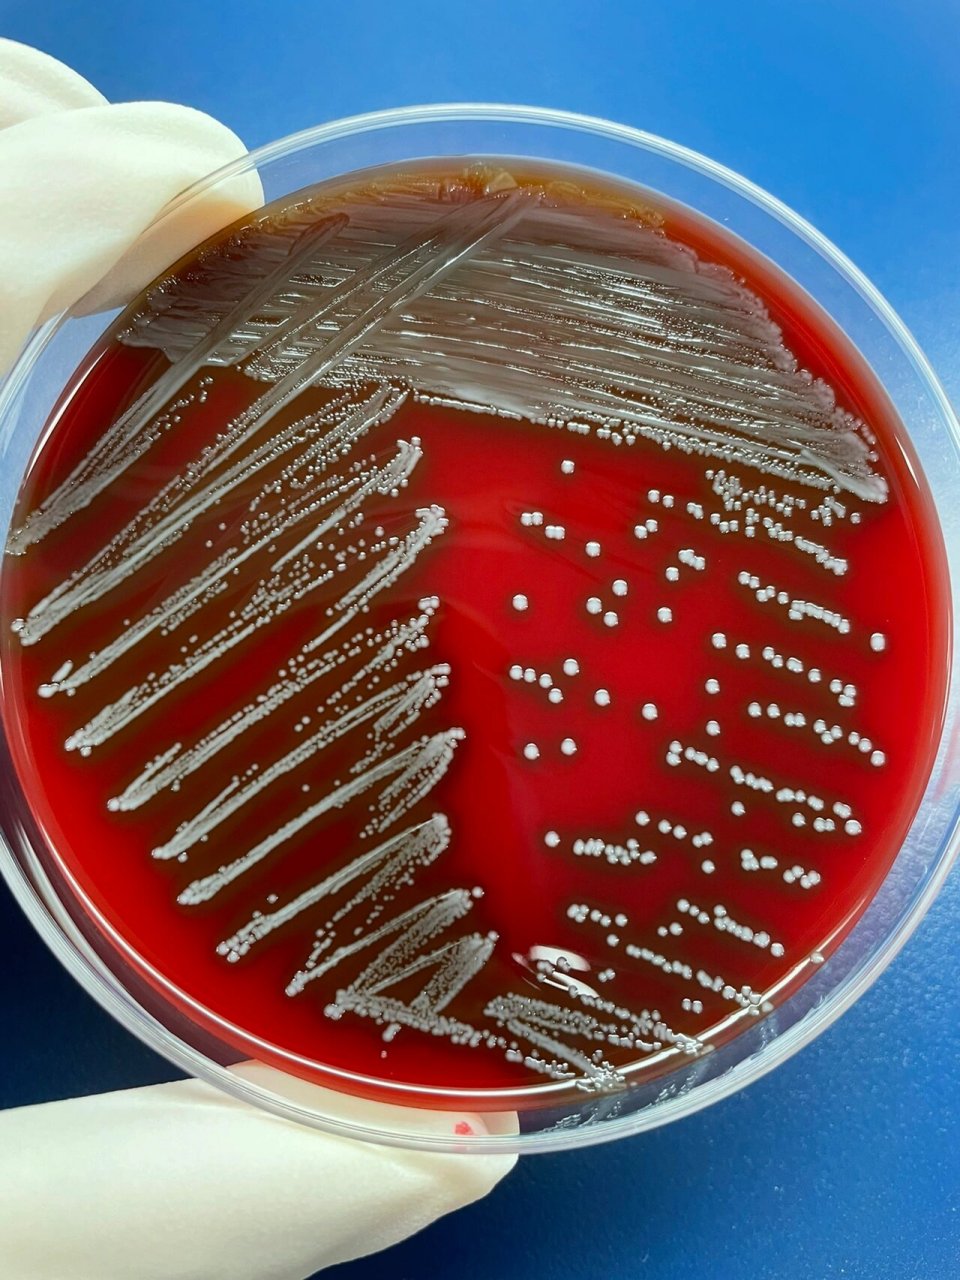
每日一菌-10 来源: 图12:分离自尿液中的屎肠球菌 图34:分离自尿液中

屎肠球菌感染

每日一菌-10 来源: 图12:分离自尿液中的屎肠球菌 图34:分离自尿液中
图片尺寸960x1280
肠球菌 两种肠球菌 屎肠球菌有一圈黑色的环而粪肠球菌没有 屎肠球菌
图片尺寸1920x2560
结肠癌早期的脓血便图
图片尺寸750x500
早上开始用林可大观预防肠球菌病,刚才发现粪便有两
图片尺寸693x520
患者,女性,泌尿道感染,涂片g阳性球菌,触酶阴性,鉴定为屎肠 - 抖音
图片尺寸1080x1920
溃疡性结肠炎活不过10年!
图片尺寸792x676
屎肠球菌anp01
图片尺寸640x465
主任提问:炎症性肠病有哪些鉴别诊断?
图片尺寸777x415
大便有棕色黏液图
图片尺寸750x500![从便便看宝宝健康[太阳] 1.蛋花汤样便——提示肠道感染, 2](https://i.ecywang.com/upload/1/img0.baidu.com/it/u=1260974196,131117959&fm=253&fmt=auto&app=138&f=JPEG?w=800&h=1077)
从便便看宝宝健康[太阳] 1.蛋花汤样便——提示肠道感染, 2
图片尺寸1016x1368
24岁小伙一天大便三次,确定肠病!4种大便异常或是身体"警报"
图片尺寸582x408
肠道寄生虫感染果酱色黏液便图
图片尺寸750x500![[向右r]形态与染色:肠球菌为革兰阳性球菌,菌体直径为0.6~2.](https://i.ecywang.com/upload/1/img2.baidu.com/it/u=155218269,1637384994&fm=253&fmt=auto&app=138&f=JPEG?w=500&h=500)
[向右r]形态与染色:肠球菌为革兰阳性球菌,菌体直径为0.6~2.
图片尺寸1080x1080
宝宝粘液便,因为肺炎住院一周打抗生素肚子腹泻,没肺炎之前也不太好
图片尺寸1280x959
肠镜下这种表现是结肠炎吗
图片尺寸4096x3072
以巨大足部溃疡为表现的坏疽性脓皮病伴克罗恩病一例报道并文献复习
图片尺寸640x282
今天知识点:球虫病 症状:初期拉稀便,接下来酱色粪便,番茄酱 - 抖音
图片尺寸370x800
屎肠球菌atcc 35667
图片尺寸640x480
北京大学口腔医院微生物 粪肠球菌 顽固性根管感染 根管治疗后的
图片尺寸1080x810
屎肠球菌和粪肠球菌的形态区别
图片尺寸1080x1439








![从便便看宝宝健康[太阳] 1.蛋花汤样便——提示肠道感染, 2](https://i.ecywang.com/upload/1/img0.baidu.com/it/u=1260974196,131117959&fm=253&fmt=auto&app=138&f=JPEG?w=800&h=1077)

![从便便看宝宝健康[太阳] 1.蛋花汤样便——提示肠道感染, 2](https://p3-pc-sign.douyinpic.com/tos-cn-i-0813/o4gz96uqmECAAAAtqCcF1BmEIODAZcAtXgfkZe~tplv-dy-aweme-images:q75.webp)






